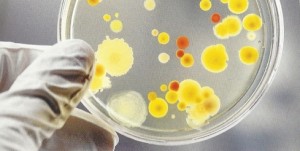

ΙΑΤΡΟΔΙΚΑΣΤΗΣ – FORENSIC SURGEON

Τα τελευταία χρόνια η ιατροδικαστική επιστήμη κερδίζει ολοένα και περισσότερο την προτίμηση των νεαρών φοιτητών της Ιατρικής. Σήμερα οι επιστήμονες έχουν την τεχνογνωσία και την τεχνολογία να εξιχνιάσουν ένα έγκλημα εντοπίζοντας τον δολοφόνο ακόμα και από τα ίχνη των παπουτσιών του που βρέθηκαν στον τόπο του εγκλήματος.
ΤΕΣΤ ΕΙΣΑΓΩΓΗΣ ΙΑΤΡΙΚΗ ΤΣΕΧΙΑ – CHARLES UNΙVERSITY- ENTRANCE TEST MEDICINE CZECH – CHARLES UNIVERSITY

Πραγματοποιείται σήμερα το τεστ εισαγωγής για την Ιατρική σχολή Πράγας. Το τεστ διεξάγεται στη σχολή μας στην Αθήνα. Το Πανεπιστήμιο Ιατρικής του Charles University Hradec Kralove είναι ιδιαίτερα φημισμένο και υπενθυμίζουμε πως η Tomi School είναι η μοναδική σχολή στην Ελλάδα για σπουδές στο εξωτερικό που είναι επίσημος συνεργάτης του εν λόγω Πανεπιστημίου.
Η ΕΞΙΣΩΣΗ ΝΤΡΕΪΚ – THE DRAKE EQUATION

Η εξίσωση Drake, που διατυπώθηκε το 1961, υπολογίζει τον αριθμό των εξωγήινων πολιτισμών που θα μπορούσαμε να εντοπίσουμε. Οι πρόσφατες ανακαλύψεις πολλών εξωπλανητών στο Γαλαξία μας έχουν αυξήσει τις πιθανότητες ύπαρξης τους. Equation Drake, formulated in 1961, calculates the number of extraterrestrial (aliens) civilizations that we could identify. Recent discoveries of many exoplanets in our galaxy […]
ΥΠΟΧΡΕΩΤΙΚΕΣ ΚΛΙΝΙΚΕΣ COMENIUS 3ο, 4ο, 5ο ΕΤΟΣ ΙΑΤΡΙΚΗ – ΟΔΟΝΤΙΑΤΡΙΚΗ – COMPULSORY CLINICAL PRACTICE COMENIUS 3rd, 4th, 5th YEAR OF STUDIES IN MEDICINE – DENTISTRY

Σύμφωνα με τους κανονισμούς του Comenius μετά την ολοκλήρωση του εκπαιδευτικού μέρους του θερινού εξαμήνου ο φοιτητής υποχρεούται να ολοκληρώσει την υποχρεωτική κλινική πρακτική με βάση τη διδακτέα ύλη μέχρι το τέλος του ακαδημαϊκού έτους 31 Αυγούστου 2015. Πιστοποιητικό παρακολούθησης της υποχρεωτικής κλινικής πρακτικής, μπορεί ο σπουδαστής να εκτυπώσει από την ιστοσελίδα ή είναι δυνατόν […]
30 credits

Ενημερώνουμε τους φοιτητές μας του Σλοβακικού Τεχνολογικού Πανεπιστημίου πως για την προαγωγή τους στο επόμενο έτος απαιτούνται 30 credits.
ΤΟ ΠΡΩΤΟ ΤΕΣΤ ΙΑΤΡΙΚΗΣ-ΟΔΟΝΤΙΑΤΡΙΚΗΣ – THE FIRST ENTRANCE TEST MEDICINE – DENTISTRY

Το πρώτο τεστ ευρωπαϊκού Πανεπιστημίου για εισαγωγή πρωτοετών Ιατρικής-Οδοντιατρικής για Έλληνες
ΕΙΔΙΚΟΤΗΤΑ ΕΥΡΩΠΑΪΚΟ ΠΑΝΕΠΙΣΤΗΜΙΟ ΚΥΠΡΟΥ – SPECIALTY EUROPEAN UNIVERSITY OF CYPRUS

ΑΠΟΦΟΙΤΟΙ ΙΑΤΡΙΚΗΣ-ΦΑΡΜΑΚΕΥΤΙΚΗΣ Οι απόφοιτοι Πτυχιούχοι Ιατρικής -Φαρμακευτικής μπορούν να παρακολουθήσουν τα παρακάτω προγράμματα Master ή Διδακτορικά του Ευρωπαϊκού Πανεπιστημίου Κύπρου:
ΚΤΗΝΙΑΤΡΙΚΗ KOSICE – UNIVERSITY OF VETERINARY MEDICINE IN KOSICE

Η Κτηνιατρική Σχολή του Κόσιτσε ανακοίνωσε ότι θα δέχεται αιτήσεις διεθνών φοιτητών για το Αγγλόφωνο τμήμα έως 29 Μαΐου. Ορίσθηκαν δύο εισαγωγικά τεστ στο Κόσιτσε στις 9 Ιουλίου και στις 24 Αυγούστου.
ΚΤΗΝΙΑΤΡΙΚΗ ΣΧΟΛΗ ΤΟΥ ΚΟΣΙΤΣΕ – UNIVERSITY OF VETERINARY MEDICINE IN KOSICE

Η Κτηνιατρική Σχολή του Κόσιτσε (Σλοβακία) είναι μία από τις πιο σύγχρονες και άρτια εξοπλισμένες Κτηνιατρικές Σχολές της Ευρώπης. Διαθέτει φάρμα με 2000 ζώα και χρησιμοποιεί τις πιο σύγχρονες μεθόδους έρευνας και διδασκαλίας. Στο Πανεπιστήμιο αυτό φοιτούν σπουδαστές από ΗΠΑ, Ισραήλ, Ιρλανδία, Γερμανία και Ελλάδα. Φέτος αποφοιτούν Έλληνες φοιτητές αφού συμπλήρωσαν επιτυχώς τις σπουδές τους. […]
ΠΑΝΕΠΙΣΤΗΜΙΟ ΤΟΥ ΚΑΡΟΛΟΥ – CHARLES UNIVERSITY
Το πρώτο τεστ εισαγωγής πρωτοετών του Πανεπιστημίου του Καρόλου (4η Σχολή Hradec Kralove) θα γίνει στην Αθήνα το Σάββατο 25 Απριλίου στα γραφεία της TOMI SCHOOL (Πανεπιστημίου 39) ώρα 9:30 π.μ. Θα συμμετέχουν 6 μαθητές μας. The first entrance test for first year candidates of Charles University (4th Faculty Hradec Kralove) will be held […]
